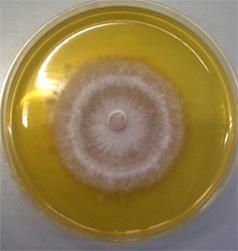

生命圏循環共生学コース
専門分野:天然物化学・生物化学
キーワード
天然物化学菌類植物共生研究の概要
天然物化学とは自然界に存在する有機化合物(天然化合物)を対象に研究する化学の一分野です。私の研究室は、天然有機化合物の単離、構造決定、合成、生物活性の有無、生合成、さらに、生物活性の発現機構の解明などを行うことで、天然物の生体における意義および生命現象との関わり、生命の仕組みなどを解明することを目的として研究を行っています。
自然界での多くの植物は糸状菌(カビやキノコ)と共存・共生して生き、その関係を介して生命現象が現れます。その現象を直に動かしているのは天然有機化合物であり、分子量が小さな分子(小分子)である場合が極めて多いです。フェアリーリング現象、マコモタケなどが挙げられます(図1)。私の研究室ではそれらの現象を天然物化学的に解明しております。

(コムラサキシメジ)


具体的な研究について
芝が大きな曲線を描いて周りに比較して色濃く繁茂し、時には成長が抑制され、後にキノコが発生するフェアリーリングという現象が知られています。「妖精が輪を作ってその中で踊る」と伝えられてきたこの現象について、最初の科学論文が報告されたのは1675年のことです。この論文がNature誌(29巻384頁1884年)に紹介されて以降330年間、妖精の正体(芝を繁茂させる原因)は謎のままででしたが、我らの研究グループは微生物と植物が織りなすこの神秘の謎に初めて化学のメスを入れ、遂にその妖精の正体を明らかにしました。実際に静岡大学キャンパスでコムラサキシメジ(Lepista sordida)によるフェアリーリングが現れたのを同大学農学部河岸教授が発見したことから、その菌類を用い研究開始のきっかけになりました。我らの研究グループは、フェアリーリングを惹起するコムラサキシメジ培養液から、シバ生長促進物質2-azahypoxanthine (AHX)とシバ成長抑制物質imidazole-4-carboxamide (ICA)の単離、同定に成功しました。両化合物が同じく合成品の存在は知られていましたが、天然由来成分の発見は初めてでした。さらにAHXは植物体内で2-aza-8-oxohypoxanthine (AOH)に代謝されることを見出しました。AOHの発見をまとめた論文が、2014 年に化学分野の総合科学雑誌である Angewandte Chemie に掲載され、「Nature」の「RESEARCH NEWS & NEWS」コーナーで論文が紹介されました。その 記事のタイトルは「fairy chemicals」でした。 以降、我々は3つの化合物をまとめて「フェアリー化合物」と命名しました。









無菌操作をする様子
学びの魅力について
菌類とは、一般にキノコ・カビ・酵母と呼ばれる生物の総称です。その中のキノコを対象とした機能性物質や薬理活性物質の天然物化学的研究は他の生物種のそれに比較して多いとは言えません。自然界では、キノコは様々な生物との相互作 用の中で生きています。キノコは植物あるいは他の菌の生長 を抑制したり、あるいは促進したりする活性が知られていますし、植物はきのこの生育を制御しています。このことは、植物とキノコとの間に化合物(フェアリー化合物など)による相互作用(クロストーク)が存在していることを示しています。この作用(活性物質)を利用すれば、植物や菌に対する成長促進剤や成長抑制・阻害剤(バイオ農薬など)の開発が可能となると考えております。このように、未知の機能性・化合物を世界で最初に発見するのはもちろん簡単ではありませんが、十分な努力と工夫と知恵が必要ですし、さらに他分野との融合・共創があれば、なにかしらの発見とその発展につながると確信しております。我々が発見したフェアリー化合物は、様々な研究に発展しております。実際、我々の天然物化学の手法だけではなく、有機合成化学、植物生理科学、遺伝子工学、情報伝達学、植物遺伝学など多方面の学問の先生とのコラボレーションをしており、勉強しながら研究を楽しくやっております。
今後の展望

シバとコムラサキシメジの共培養
「植物ホルモン」とは、植物において微量に作用する生理活性物質またはシグナル伝達物質を意味します。これまでに植物ホルモンとして認識されている物質は約10種類あります。それに新たなページを加える研究に取り組んでいます。 先に述べたように、20年ほど前に芝生で見つけた「妖精の輪」のことです。 FCsを新規植物ホルモンとして位置づけ、植物のストレス生理学あるいは新規植物成長調節物質の開発研究に新たな切り口を提供することが期待されています。これらの研究のように、新規リード化合物の探索をすることで、大きな研究につながりました。多くの生物の全ゲノム情報が判明していますが、生命現象を直接制御しているのは小分子であり、このことが天然物化学研究の重要性を示しています。現在は、生物間の共存・共生下の現象に興味があり、その解明にも挑戦しています。
受験生へのメッセージ
グローバル共創科学部には、特に生命圏循環共生学コースには私の専門である天然物化学・生物化学を初め、複合材料科学・高分子化学、国際法、発生生物学、材料工学、環境社会学・環境倫理学、環境生物化学、分子進化学・情報生物学、環境経済学・環境政策などの様々な専門分野の先生がいます。多面的に考えて問題を解決する能力を身につけませんか? 天然物化学的な手法を用い、受験生皆様の好奇心、想像力、観察力で、様々な生命現象・環境問題を科学的に解明し、その原因化合物を発見しましょう。期待しています。

